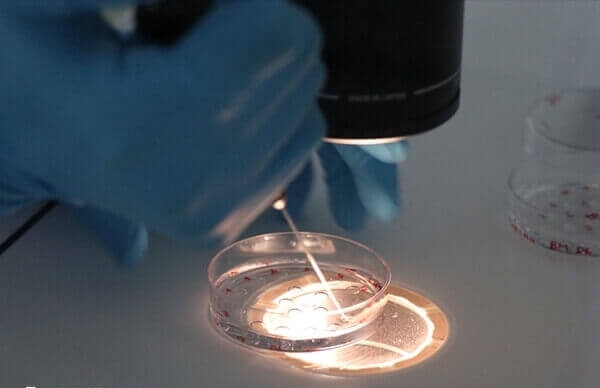

导读: 患者做一代试管婴儿费用并无固定标准,大概在2-4万元不等,具体还要根据患者身体情况及治疗情况而定,如果患者身体状态较好,无其它异常疾病,且做一代试管一次就成功着床了,那么最低只需要花1-3万元,但如果患者促排卵不顺利,或是存在其它疾病,那么收费会相应增加,约3-5万元不等。
患者做一代试管婴儿费用并无固定标准,大概在2-4万元不等,具体还要根据患者身体情况及治疗情况而定,如果患者身体状态较好,无其它异常疾病,且做一代试管一次就成功着床了,那么最低只需要花1-3万元,但如果患者促排卵不顺利,或是存在其它疾病,那么收费会相应增加,约3-5万元不等。
一代试管婴儿费用多少
试管婴儿是目前备孕困难的夫妻生孩子的一个选择途径,随着试管技术的发展,大家已经对一代试管婴儿有所了解,大多数人也都会选择它,但是很多人做一代试管婴儿时,却并不是特别清楚一代试管婴儿收费是怎样的,若有患者对此感兴趣,那么可参考下列内容了解。
1、术前检查费
做一代试管婴儿治疗的患者,在治疗前需要进行全面的身体检查,包括男方精液、血液检查,女方生殖系统能力评估,除此之外还要检查染色体、血液检查等,这部分收费大概在2000-4000元不等。
2、促排卵药物费
在一代试管婴儿技术中,需要对女性进行促排卵治疗,以便获得更多的优质卵子,目前患者使用的促排卵药物费用大约在5000-15000元之间,而具体费用取决于女性所使用的药物种类及剂量,具体并无固定标准。

3、实验室培养费
患者做一代试管促排取卵后,需要将精子和卵子进行体外培养,一般一代试管实验室体外培养收费大概在10000元左右,具体还要根据实际胚胎培养情况为准。
4、手术费
一代试管手术费包括取卵取精、胚胎移植等,这部分收费大概在5000-10000元不等,具体收费还要根据手术类型、是否使用麻醉等多个方面判断。
一代试管婴儿整体花费大概在2-3万元不等,具体还要根据实际收费为准,如果患者做一代试管治疗期间,其促排卵、取卵取精及移植等方面存在异常,那么可能增加治疗次数,这时也就会增加相应的费用,导致实际收费可能会更高些。
上一篇:
取卵要花多少钱
下一篇:
试管一代需要什么条件
标签:
好孕交流群 分享心理 链接关系 共同目标
备孕优生
助您好孕多多
不孕不育
助您好孕多多










